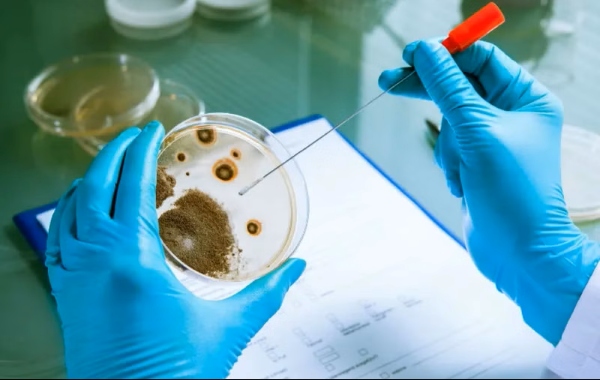
Kiểm tra tổng số vi sinh vật hiếu khí giúp phát hiện sớm nguy cơ nhiễm khuẩn

Trong chuỗi sản xuất thực phẩm, tổng số vi sinh vật hiếu khí trong thực phẩm đóng vai trò như một “chỉ báo nhanh” về điều kiện vệ sinh và bảo quản. Việc kiểm soát tốt chỉ tiêu này giúp kéo dài thời hạn sử dụng và đảm bảo an toàn. Bài viết này, MT sẽ giúp bạn hiểu rõ vai trò và cách quản lý chỉ tiêu này.

Ý nghĩa của việc kiểm tra tổng số vi sinh vật hiếu khí trong thực phẩm
Tổng số vi sinh vật hiếu khí là tổng số các tế bào vi khuẩn, nấm men, nấm mốc có khả năng hình thành khuẩn lạc trong môi trường thạch dinh dưỡng ở điều kiện có oxy (hiếu khí) và nhiệt độ ủ xác định. Việc kiểm tra chỉ số này mang lại những ý nghĩa chiến lược sau:
- Đánh giá mức độ vệ sinh tổng thể: Chỉ số APC cao thường là dấu hiệu cho thấy quy trình sản xuất, chế biến hoặc bảo quản chưa đảm bảo vệ sinh. Nó cho thấy nguyên liệu đầu vào có thể bị nhiễm bẩn hoặc thiết bị sản xuất chưa được khử trùng triệt để.
- Dự báo thời hạn sử dụng (Shelf-life): Số lượng vi sinh vật hiếu khí tỷ lệ nghịch với thời gian bảo quản. Khi chỉ số này vượt ngưỡng, thực phẩm sẽ nhanh chóng bị biến chất, ôi thiu, gây tổn thất kinh tế cho doanh nghiệp.
- Kiểm soát quy trình HACCP: Trong hệ thống quản lý an toàn thực phẩm, APC được dùng làm chỉ số xác nhận (verification) để xem các điểm kiểm soát tới hạn (CCP) có hoạt động hiệu quả hay không.
- Tuân thủ quy chuẩn pháp luật: Mọi sản phẩm thực phẩm khi công bố chất lượng đều phải đáp ứng các chỉ tiêu vi sinh theo quy định của Bộ Y tế hoặc các tiêu chuẩn quốc tế (ISO, CODEX).
Quy định về giới hạn tổng số vi sinh vật hiếu khí trong thực phẩm
Mỗi loại thực phẩm có đặc tính lý hóa và quy trình chế biến khác nhau, do đó giới hạn cho phép của tổng số vi sinh vật hiếu khí cũng khác nhau. Tại Việt Nam, các quy định này thường dựa trên QCVN 8-3:2012/BYT và các tiêu chuẩn TCVN liên quan.
Đối với các nhóm thực phẩm phổ biến:
- Thực phẩm chín (ăn liền): Yêu cầu rất khắt khe, thường giới hạn ở mức 10^4 đến 10^5 CFU/g. Nếu vượt quá mức này, sản phẩm bị coi là không đạt chuẩn vệ sinh.
- Thịt tươi sống và thủy sản: Do đặc thù môi trường giàu dinh dưỡng, giới hạn thường dao động từ 10^5 đến 10^6 CFU/g tùy loại.
- Sữa và sản phẩm từ sữa: Các loại sữa thanh trùng có giới hạn thấp hơn nhiều so với các loại phô mai lên men tự nhiên.
- Gia vị và thảo mộc khô: Do đặc tính khô, giới hạn có thể linh hoạt hơn nhưng vẫn cần kiểm soát để tránh nhiễm chéo sang các thực phẩm khác khi chế biến.
Việc hiểu rõ ngưỡng giới hạn giúp doanh nghiệp tự tin trong khâu kiểm soát nội bộ và tránh các rủi ro pháp lý khi cơ quan chức năng thanh tra.

Đọc thêm các bài viết liên quan:
Ảnh hưởng của tổng số vi sinh vật hiếu khí đến chất lượng thực phẩm
Sự hiện diện quá mức của vi sinh vật hiếu khí gây ra những tác động tiêu cực trực tiếp đến trải nghiệm người dùng và giá trị thương mại:
Biến đổi tính chất cảm quan
Đây là dấu hiệu dễ nhận biết nhất. Vi sinh vật phân hủy các thành phần protein, lipid và carbohydrate trong thực phẩm, dẫn đến:
- Mùi hôi: Sự giải phóng khí H2S, amoniac do quá trình phân hủy đạm.
- Màu sắc: Xuất hiện các đốm màu, thực phẩm bị xỉn màu hoặc đổi màu lạ.
- Cấu trúc: Thực phẩm trở nên nhớt, mềm nhũn hoặc bị tách lớp (đối với các dạng lỏng).

Giảm giá trị dinh dưỡng
Vi sinh vật sử dụng các vitamin, khoáng chất và các acid amin trong thực phẩm để làm nguồn thức ăn cho quá trình nhân đôi tế bào. Điều này khiến thực phẩm “rỗng” dần về mặt dinh dưỡng dù vẻ ngoài có thể chưa biến đổi hoàn toàn. Để hiểu rõ hơn vai trò của các thành phần dinh dưỡng trong môi trường sinh học, bạn có thể tham khảo thêm về khoáng đa lượng và khoáng vi lượng trong nuôi cấy mô, đây là những yếu tố quan trọng giúp kiểm soát sự phát triển của tế bào và vi sinh vật trong các hệ thống nuôi cấy.
Nguy cơ gây ngộ độc thực phẩm
Mặc dù không phải tất cả vi sinh vật hiếu khí đều là tác nhân gây bệnh (pathogen), nhưng số lượng APC quá cao là “hồi chuông cảnh báo” về sự hiện diện tiềm tàng của các loại vi khuẩn nguy hiểm như Salmonella, E. coli hay Staphylococcus aureus.
Phương pháp kiểm tra tổng số vi sinh vật hiếu khí
Việc xác định tổng số vi sinh vật hiếu khí (APC) là bước quan trọng trong kiểm soát chất lượng thực phẩm, giúp đánh giá mức độ nhiễm vi sinh và hiệu quả vệ sinh trong quá trình sản xuất. Tùy theo loại mẫu và yêu cầu phân tích, phòng thí nghiệm có thể lựa chọn các phương pháp phù hợp, từ truyền thống đến hiện đại.
Các phương pháp phổ biến gồm:
- Phương pháp đổ đĩa (Pour Plate): Mẫu được pha loãng, trộn với môi trường thạch và ủ ở 30–37°C trong 24–72 giờ. Sau đó đếm số khuẩn lạc để tính mật độ vi sinh vật.
- Phương pháp trải đĩa (Spread Plate): Mẫu được nhỏ lên bề mặt thạch và trải đều. Phù hợp khi cần quan sát khuẩn lạc rõ ràng, tách biệt.
- Phương pháp màng lọc (Membrane Filtration): Mẫu lỏng được lọc qua màng, sau đó ủ trên môi trường nuôi cấy. Hiệu quả với mẫu có mật độ vi sinh thấp.
- Phương pháp nhanh (Rapid Methods): Bao gồm ATP bioluminescence, PCR hoặc hệ thống tự động, cho kết quả nhanh và hỗ trợ kiểm soát theo thời gian thực.

Biện pháp kiểm soát vi sinh vật trong thực phẩm
Kiểm soát vi sinh vật là yếu tố then chốt để đảm bảo chất lượng và an toàn thực phẩm trong toàn bộ chuỗi sản xuất. Thay vì xử lý khi đã nhiễm, doanh nghiệp cần chủ động phòng ngừa ngay từ nguyên liệu đầu vào đến thành phẩm, kết hợp nhiều giải pháp đồng bộ.
- Kiểm soát nguyên liệu đầu vào: Lựa chọn nguồn cung đạt chuẩn, kiểm tra vi sinh định kỳ và bảo quản đúng điều kiện để hạn chế nhiễm ban đầu.
- Vệ sinh nhà xưởng và thiết bị: Áp dụng SSOP, sử dụng chất sát trùng phù hợp và đánh giá hiệu quả làm sạch nhằm ngăn nhiễm chéo.
- Kiểm soát nhiệt độ và độ ẩm: Duy trì chuỗi lạnh, hạn chế dao động nhiệt và kiểm soát độ ẩm để kìm hãm sự phát triển của vi sinh vật.
- Áp dụng hệ thống quản lý chất lượng: Triển khai HACCP, GMP, ISO 22000 để xác định và kiểm soát các điểm nguy cơ vi sinh.
- Đào tạo nhân sự: Nâng cao ý thức vệ sinh cá nhân, chuẩn hóa thao tác và kiểm tra định kỳ để giảm rủi ro từ con người.
- Ứng dụng công nghệ bảo quản: Sử dụng bao gói khí quyển biến đổi (MAP), chiếu xạ hoặc chất bảo quản an toàn để kéo dài thời gian sử dụng.

Kiểm soát tổng số vi sinh vật hiếu khí trong thực phẩm không chỉ đáp ứng quy định mà còn nâng cao uy tín thương hiệu. Doanh nghiệp cần kết hợp kiểm nghiệm và vận hành chuẩn hóa để đạt hiệu quả bền vững. MT sẵn sàng đồng hành cùng bạn trong việc xây dựng hệ thống kiểm soát vi sinh toàn diện và chuyên sâu.
Thông tin liên hệ:
- Hotline: 0767 067 567
- Địa chỉ: TK40/10 Đường Trần Hưng Đạo, Phường Cầu Ông Lãnh, Thành phố Hồ Chí Minh, Việt Nam.
- Email: infor@mtenequip.com
